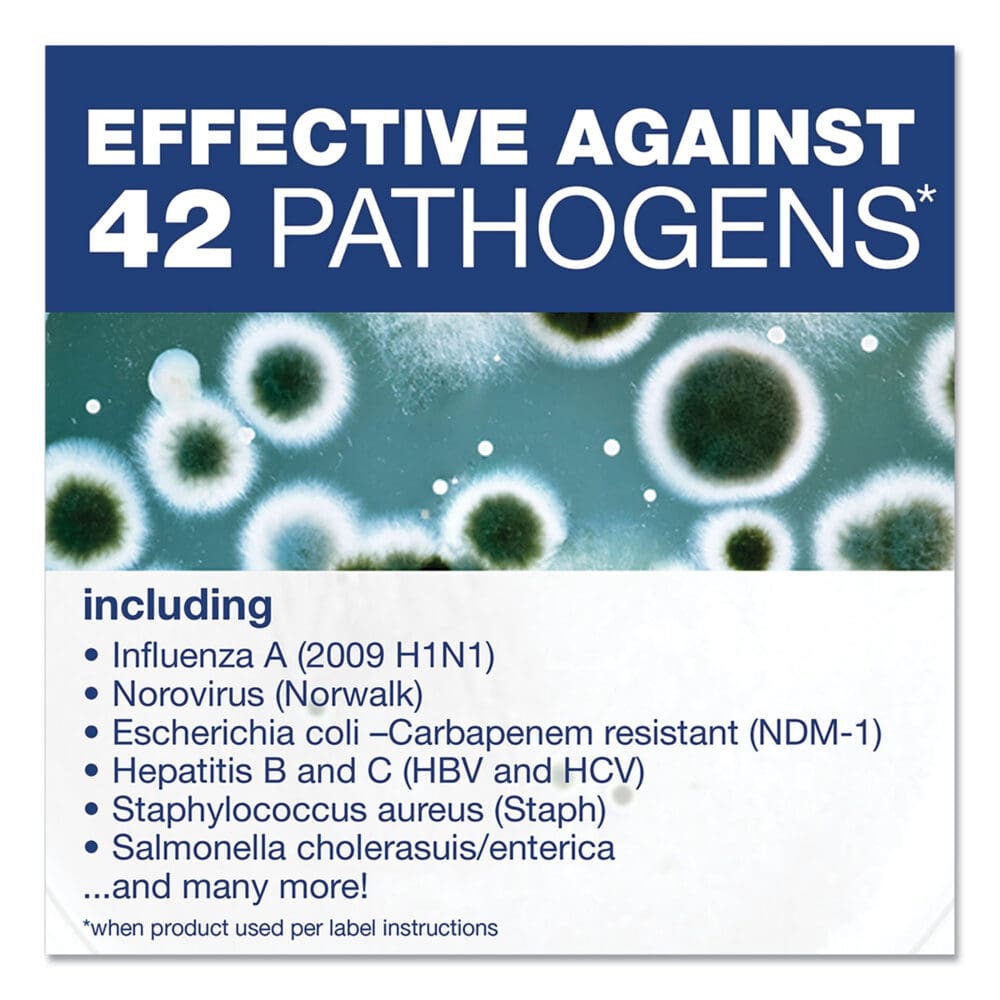
Disinfecting Cleaner with Bleach, 1 gal Bottle - Image 4

Disinfecting Cleaner with Bleach, 1 gal Bottle
- Kills 99.9% of bacteria and viruses in one minute (see EPA master label for full list of organisms and contact times).
- Combines the power of a heavy-duty restroom cleaner and surface deodorizer.
- Removes greasy soap scum with 50% fewer strokes.
- Included on the EPA List N: disinfectants for use against the novel coronavirus SARS-CoV-2.
- Cleans and sanitizes in one step when used per label instructions.
- Works great as a bathroom disinfectant (when used according to disinfecting instructions) on toilets, sinks, chrome, tile, tubs and fiberglass.
$41.26
/ EADescription
Comet Disinfecting Cleaner With Bleach is a two-in-one all purpose cleaner formula that combines the cleaning power of heavy-duty detergents with the stain-removal power of bleach. A hospital-use disinfectant when used per label instructions, It is effective as a disinfectant in 60 seconds against Hepatitis A and C, Norovirus, and 39 other microorganisms (See EPA master label for full list of organisms and contact times. Not yet approved in CA). Comet Disinfecting Cleaner With Bleach contains no abrasives and uses remarkable cleaning technologies that may be used to clean customer and employee restrooms, tracked-in dirt and scuffmarks, kitchen-area stains, plastic trash containers, greasy equipment containers and other surfaces.
Product details
| Weight | 28 lbs |
|---|---|
| Dimensions | 12 × 6.8 × 4.8 in |
| Global Product Type | Disinfectants/Cleaners |
| Application | Disinfectant/Cleaner |
| Applicable Material | Ceramics; Enamel; Fiberglass; Glass; Grout; Laminates; Metal; Plastic; Sealed/Engineered Stone; Vinyl |
| Chemical Compound | Bleach |
| Dirt Types | Bacteria; Fungus; Germs; Grease; Grime; Mildew; Mineral Scale; Organic Matter; Soap Scum; Water-Based Soil |
| Scent | Fresh |
| Physical Form | Liquid |
| Product Packaging | Bottle |
| Volume Capacity | 1 gal |
| Compliance Standards | EPA Reg. No. 3573-77; EPA List N; LEED Applicable |
| Disclaimer Statement | See EPA master label for full list of organisms and contact times. Not yet approved in CA. |